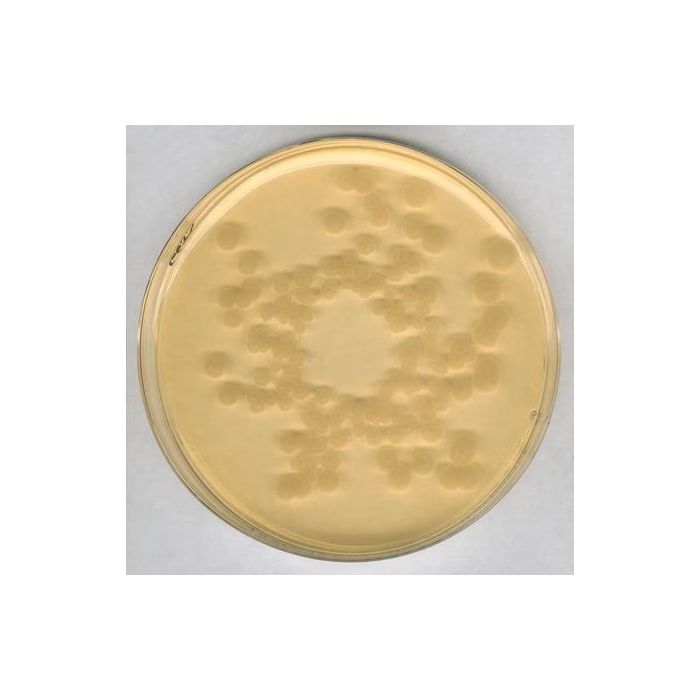
Merck Millipore Tryptic Soy Agar - Dehydrated Culture Media for Microbiology (500g Pack)

Equipment
Essential Equipment
Accident and Emergency
Dermatology
Diagnostic Equipment
Disinfection and Sterilisation
ECG Equipment
ENT and Ophthalmology
General Diagnostics
Hand and Surgery Hygiene
Injection & Infusion Materials
Instruments
Medical Bags
Minor Surgery, Single Use Instruments & Procedure Packs
Pain Management
Point of Care Testing
Refrigeration - NEW RANGE
Respiratory Care
Special Offers & Clearance
Home Use Devices
Reusable Instruments & Trays
Scales and Height Measures
Sterilisation Accessories
Surgery Furniture
Sutures
Women's Health
Wound Care
Wound Closure & Minor Surgery Equipment
Consumables
Everyday Essentials
Accident & Emergency
Bandages and Dressings
Dermatology
Disinfection and Sterilisation
Disposables
ECG Equipment
ENT and Ophthalmology
General Diagnostics
General Surgery Supplies
Gloves
Injection & Infusion Materials
Minor Surgery, Single Use Instruments & Procedure Packs
Special Offers & Clearance


Services




At Promed, we are dedicated to delivering top-quality service and accredited in-house medical equipment support to primary care practices, clinics, and corporate clients.
Not sure which service suits you? Contact our Customer Service Team.